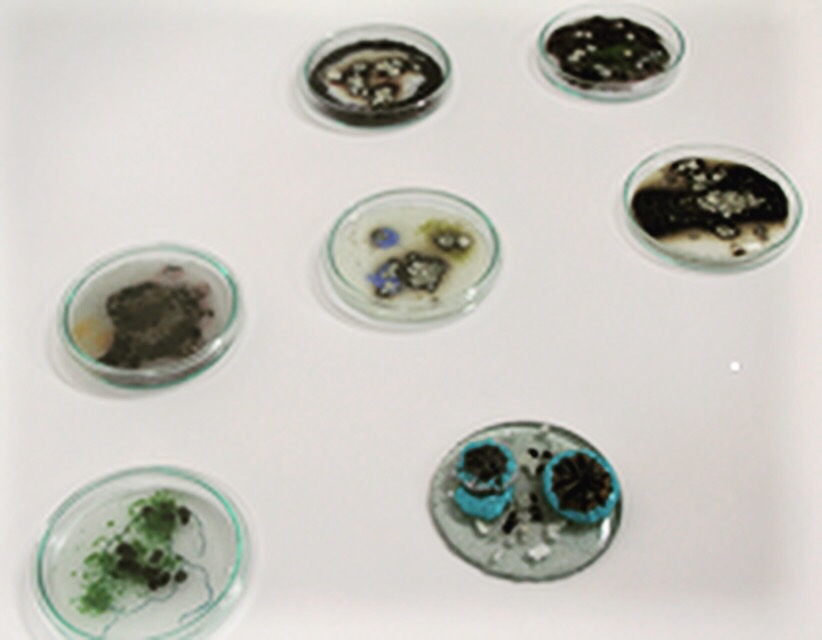
Developments in Medicine

Current Exhibition
“Graduates Work the Next Generation”- curated by The Contemporary Glass Society
“Graduates Work the Next Generation”- curated by The Contemporary Glass Society
This exhibition aims to show the ingenuity and breadth of work from the next generation of makers. Due to Covid 19 and the disruption of course work last year, all students graduating from a British & Irish accredited course in 2020 and 2021 were be eligible to enter this show.
27 (plus 1 belated) extraordinary glass graduates boast an eclectic array of glass art that has never been shown like this before!
CGS are extremely proud to be exhibiting both these glass graduates and their work in this format for the first time.
11th October – 20th November 2021, then permanently in the CGS online gallery.

Launched on:11th October 2021

Artist:Helen Slater Stokes
Email:helenslaterglass@aol.com www.helenslaterglass.com @helenslaterglass Inst @helenslaterglass Twitter: @hslaterglass
Title:Virtual Landscape
Contact: The Royal College of Art. PHD.
Price: £3950.00
Photo Credit: Esta Segarra
Dimension: 29 x 24 x 5 cm
Shop: https://www.artwavewest.com/gallery-artists/helen-slater/
TAKE PART IN NEXT EXHIBITION HEREArtist:Marianne Le Gallo
Email:mariannelegallo.com @mariannelegallostudio
Title:Gunnera Manicata 2021
Details: Glass MFA 2021, Edinburgh College of Art
Price: Price on demand to a gallery/museum where the work will be publicly accessible/exhibited (NFS to private collections).
Dimension: 40cm x 40cm at its widest, 5cm depth & 6.5 Kgs.
Shop: https://www.graduateshow.eca.ed.ac.uk/portfolio/marianne-le-gallo
TAKE PART IN NEXT EXHIBITION HEREArtist:Giles Fearon
Email: gilesfearon1@gmail.com https://gilesfearon1.wixsite.com/gilesfearon
Title:Natural Fluidity
It seemed a natural progression for me to want to represent the ‘mindful breath’ which is an established part of meditative practice.This symbolized for me how this work should be made.
Contact: Manchester Metropolitan University- Three Dimensional Design
Price: £3000 (all three + base)
Dimension: D25-35cm Base: L75cm x W40cm
TAKE PART IN NEXT EXHIBITION HEREArtist:Catherine Dunstan
Email:@catherinedunstanglass www.catherinedunstanglass.co.uk 07955002776 Catherine@catherinedunstanglass.co.uk
Title:Support System
They are jewel-like, imperfect in their irregularity but polished to a full shine. I feel like they’re saying, ‘We tried, we failed; but we showed up anyway.’ The parallel of that feeling to how I feel about my experience of motherhood (which is a big driver behind my practice) was obvious and easy to align. I feel these polished fragments quite literally stand up proudly holding space for the reality of processing difficult experiences, feeling like a failure, and then still showing up.
Details: @catherinedunstanglass www.catherinedunstanglass.co.uk 07955002776 Catherine@catherinedunstanglass.co.uk
Price: (sold as pair) £175
TAKE PART IN NEXT EXHIBITION HEREArtist:Grace Allen
Email: Instagram @Grace.a_crafts https://graceallencrafts.wixsite.com/glass Grace.e.allen98@gmail.com
Title:Coursing Onward
Contact: De Montfort University. Design crafts Ba (Hons)
Dimension: Green piece 120mm tall, top diameter 70mm Pink piece 120mm tall, top diameter 70mm Blue piece 180mm, top diameter 55mm
TAKE PART IN NEXT EXHIBITION HEREArtist:Rosie Perrett
Email:rosieperrett4@gmail.com. Instagram - @rosieperrettdesign. Facebook – RosiePerrettDesign. Artsthreads : https://www.artsthread.com/profile/rosieperrett/
Title:The Influence of Colour.
Contact: Demontfort University, Leicester.
Details: One piece of blown glass work, first image full piece, second image close up. Size of glass work : 18x15cm.
Photo Credit: Matte Studios UK
Dimension: BA Honours in Design Crafts, Class of 2021.
TAKE PART IN NEXT EXHIBITION HEREArtist:Wei Ding
Email:Ins: ding.1117 Facebook: Wei Ding bh70dr@student.sunderland.ac.uk
Title:A Love Letter To Myself
Price: 1500 euros
Photo Credit: Cate Watkinson
Dimension: Glass and Ceramic, 107cm×3cm×107cm
TAKE PART IN NEXT EXHIBITION HEREArtist:Ben Bavin
Email:benbavin.glass@gmail.com https://benbglass.com @benbglass Instagram
Title:SIMULACRUM
Contact: Plymouth College of Art
Details: H40cm W10cm D10cm X5 4800g
Photo Credit: Abbie Gray (@abbiegrayphotography on instagram https://www.abbiegrayphotography.com/ )
Dimension: BA (Hons) Ceramics & Glass
TAKE PART IN NEXT EXHIBITION HEREArtist:Kay Ford
Email:kjford@gmail.com.
Title:Developments in Medicine
University Centre Hastings
1st class honours BA Designer Maker
Dimension: 10cm diameter
Shop: www.kayfordglassandmetal.com
TAKE PART IN NEXT EXHIBITION HEREArtist:Charlie Vinten
Email: charliemichaela99@hotmail.com Instagram: @cvinten_craft Facebook: CVinten Crafting
Title:Take a Breath
Contact: De Montfort University
Details: 5 layers of glass: clear, blue, white and infused flowers, pink and purple, clear.
Price: £225
Photo Credit: Oliver Freemantle
Dimension: 25x10x10cm
TAKE PART IN NEXT EXHIBITION HEREArtist:Sacha Delabre
Email:sachadela@gmail.com sachadelabre.uk @sacha_dela__
Title:Bon Appetit
Price: £200
Photo Credit: Marco Gongalves
TAKE PART IN NEXT EXHIBITION HEREArtist:Luisa Carmen Martin Lopez
Email:lcmartinlopez@gmail.com
Title:The Four Seasons
Photo Credit: Michael Redina
Dimension: Four blocks of 10x7x2 cm each. Printed, over layered and fused glass. One of in Float glass, another in Bullseye and two in Spectrum.
TAKE PART IN NEXT EXHIBITION HEREArtist:Kate Courtney-Taylor
Title:Untethered
Details: kate_courtney_taylor@hotmail.co.uk https://www.katecourtney-taylor.co.uk/
Price: NFS
Dimension: 36x 29 x 70cm (HxDxW)......
TAKE PART IN NEXT EXHIBITION HEREArtist:Georgia Stone
Email:ggstone@hotmail.co.uk www.georgiastoneart.com/bio Instagram: @georgegstone
Title:Dancing Vessels
Contact: Farnham, UCA - Glass, BA (Hons)
Details: Blown Glass, Two vessels, Approx size: On Right (30cm H) On Left (25cm H)
TAKE PART IN NEXT EXHIBITION HEREArtist:Ossin Hanrahan
Email:ossin.hanrahan@mycit.ie https://www.instagram.com/ossinhanrahan/
Title:Meandering lines
In this piece I implemented times tables patterns for the linear designs and the chaos of kiln gods who helped to manipulate the overall shape into something more than I originally planned. This piece has changed several times in an organic way as the materials demanded.
Contact: Crawford College of art and design CIT. BA honours Contemporary Applied Art
Details: cast glass, 23x12x40cm, crystal clear bullseye glass
Price: £6000
Photo Credit: Philip Williums
TAKE PART IN NEXT EXHIBITION HEREArtist:Alison McKenna
Email: alisonmc1985@hotmail.com Instagram: https://www.instagram.com/alison_wonderlandart/
Title:500 Steps : Center & Balance
Contact: National College of Art & Design, Dublin.BA Fine Art.
Details: Collection of 12 A3 Fine Art photographic Prints
Price: €80 per A3 print un- framed
TAKE PART IN NEXT EXHIBITION HEREArtist:Yixue Yang
Email:yangyixuenc@163.com
Title:Unknown
Contact: Facebook: Yixue Young Ins:young.7902
Details: Glass and Mirror
Price: £2500
Photo Credit: Dave Williams
Dimension: 180cm x 160cm x 60cm
TAKE PART IN NEXT EXHIBITION HEREArtist:Jacqui Farrell-Fowler
Email:Jacqui.fowler@btopenworld.com www.jacquifowler.co.uk Inst: @jacquifowlerglass
Title:A meditation on womanhood
Contact: University of Wales, Trinity St David (2017-2020)
Details: BA Hons Architectural Glass (1st Class)
Price: NFS
Dimension: A circular leaded piece, 300mm in diameter. Sandblasted, acid etched and hand painted with vitreous paint and enamels.
TAKE PART IN NEXT EXHIBITION HEREArtist:Áine Ryan
Email:aineryan2015@gmail.com https://aineryanart.wordpress.com/ https://www.instagram.com/aine_ryan_art/
Title:Bound
Contact: MTU Crawford College of Art and Design
Details: cast glass, discarded wellington, scraith sod from nearby bog
Price: €660
Photo Credit: Sean Daly
Dimension: L210cm x W6cm x H5cm
Shop: Bachelor of Arts in Contemporary Applied Art
TAKE PART IN NEXT EXHIBITION HEREArtist:Moonju Suh
Email:monicarhapsody@outlook.com / Instagram: @playful_temperature
Title:Happiness Diary
I believe people often hide their true emotions and personalities. There are many reasons for people hiding their true feelings. But, I argue, one of the most plausible reasons could be that none of us willingly expose their weakness or vulnerabilities.
Contact: Edinburgh College of Art.................. Type of qualification…...........Master of Fine Arts
Price: £1700
Dimension: 9 x 9 x 16 (cm)
TAKE PART IN NEXT EXHIBITION HEREArtist:Belinda King
Email:@bjk_designs on Instagram
Title:Fraternal
Contact: De Montfort University
Price: NFS
Photo Credit: Matte Studio
Dimension: 20cm x 27.5cm
Shop: BA (Hons) Design Crafts
TAKE PART IN NEXT EXHIBITION HEREArtist:Nanu Hodson
Email:nanuhodson223@gmail.com
Title:Design Migration
Although it is of Indian origin, the Paisley was named in Scotland which to me represents the changing nature of design and how it can be translated across cultures.
Contact: Morley College, London
Details: Level 3 BTEC in Art & Design
Photo Credit: Clair Griffiths
Dimension: Uneven strip cut contruction fired within a steel former, the piece is 20cm from tip to base
TAKE PART IN NEXT EXHIBITION HEREArtist:Steven Graham
Email:steven@in-glass.uk https://www.in-glass.uk https://www.facebook.com/stevengrahaminglass/ https://www.instagram.com/steveninglass/
Title:Allison
This panel was commissioned in memory of Allison, who lost her fight with cancer. Having spent time speaking with the client, and listening to the many wonderful stories of Allison, I worked on designs that captured those aspects of her life that were important to her and which resonate her personality:
Yellow roses – These were Allison’s favourite flower and featured in her wedding bouquet
Family names and relevant dates have been entwined into the flourishing rose bush background
VW logo – her love of the classic camper van
Candles – a gift guaranteed to bring a smile to her face
Nice cakes – all friends and family associated a good day out with Allison would involve quality cakes.
Bumble bee – the logo for the Beatson Cancer Centre, Glasgow where Allison received her treatment and for whom she and her friends and family assisted with fund raising
Neck scarves – Allison had a scarf for every occasion, another gift idea
The overall design reflects the client’s interest in the art deco era, and with Alphonse Mucha after their visit to Prague. This design created a foil for so many disparate elements to be combined into a pleasing and respectful aesthetic, which reflects her life and personality.
University of Stirling Batchelor of Arts with Honours in Art & Design
Photo Credit: Ian Marshall
Dimension: 397mm x 447mm
TAKE PART IN NEXT EXHIBITION HEREArtist:Elizabeth Simms
Email:- simmse@hotmail.com - @e.s.design_ (instergram)
Title:Menstr-hood’
(Hand blown Glass, sandblasted, iron filings, sediment)
‘Broken Body of a Bloated Beast’ 2021
(Mould blown glass, life cast, iron filings, sediment)
‘Unstained Youth’ 2021
(Mould blown glass, life cast, sandblasted, iron filings, sediment)
This series features life-sized female body forms casted from the artist herself and mould blown using glass. These three pieces (left to right) ‘Outgrown Home’, ‘Broken Body of a Bloated Beast’ and ‘Unstained Youth’ express the progression of the self from childhood through to puberty. The series was inspired by how it feels to suddenly be faced with dealing with your monthly menstrual cycle and how it can impact the self and body.
This sculptural interpretation of the struggles which come with menstruation aims to initiate and encourage everyone of all genders and ages to share their own experiences and learn from others.
Contact: Plymouth College of Art
Photo Credit: Lorna Absley
Dimension: BA (Hons) 3D Design Crafts
TAKE PART IN NEXT EXHIBITION HEREArtist:Gemma Hollis
Email: @gemmahollisglass Facebook: Gemma Hollis Glass gemmahollisglass@gmail.com
Title:What a bird watcher sees
Left piece- The Bumbarrels. Three sculpted blown glass forms, with pink, black and white spirals. Sitting upon a sustainably sourced yew base
Height:19cm Width: 20cm Depth:14.5cm
Middle- The Nuthatch. Sculpted blown glass form, with blue and light pink spirals. Sitting upon a sustainably sourced yew base.
Height:14cm Width:15cm Depth:10cm
Right- Blackbird. Sculpted blown glass with black and yellow spirals. Sitting upon a sustainably sourced yew base.
Height: 23cm Width:26.5cm Depth: 22cm
Contact: De Montfort University, Leicester Design Crafts Ba (Hons)
Details: The Bumbarrels. Three sculpted blown glass forms, with pink, black and white spirals. Sitting upon a sustainably sourced yew base
Photo Credit: Olly Freemantle
Dimension: H:19cm W: 20cm D:14.5cm H:14cm W:15cm D:10cm H: 23cm W:26.5cm D: 22cm
TAKE PART IN NEXT EXHIBITION HEREArtist:Yixue Yang
Email:yangyixuenc@163.com Facebook: Yixue Young Ins:young.7902
Title:Progression
Details: Glass &ink
Price: £3000
Dimension: 280cm x70cm x25cm
TAKE PART IN NEXT EXHIBITION HEREArtist:Pratibha Mistry
Email:pratibha_mistry@hotmail.co.uk #pratibhamistryglass
Title:Hypoxia (2020)
Contact: University of the Creative Arts. MA Glass
Details: Glass (pâte de verre) mounted with metal dissection pins
Price: NFS
Dimension: 380 x 390 mm
TAKE PART IN NEXT EXHIBITION HEREArtist:Wai Yan Choi
Email:Phone: +85290206984/ 07591541241 Email: Waiyan.choi@network.rca.ac.uk Website: waiyanchoi.com Instagram: https://www.instagram.com/waiyanchoiglass/
Title:Inner Boundaries
Stimutaniously, I used material metaphorically : the flawlwss transparency of glass to represent the environment and the metal to represent man made pollutants that's break the balance of the ecosystem. If combined in certain ways, they are destructive to each other. Yet, under controlled circumstances, environment and human development can coexist and even stimulate something new. I want to use my work to convey a positive vision for the current pandemic and environmental pollution crisis. Our life will return to a new normal, and we can find a way to coexist with nature before the apocalypse arrives.
Contact: Royal College of Arts
Details: 4 x 5 x 7.5 cm per element (Overall dimensions vary with different compositions)
Price: £2500 for the whole set of 23 Cubes and Stands
Photo Credit: Junwei Chen
Dimension: Ceramics and Glass MA 2021
TAKE PART IN NEXT EXHIBITION HERE

Artist:Helen Slater Stokes
Email:helenslaterglass@aol.com www.helenslaterglass.com @helenslaterglass Inst @helenslaterglass Twitter: @hslaterglass
Title:Virtual Landscape
Contact: The Royal College of Art. PHD.
Price: £3950.00
Photo Credit: Esta Segarra
Dimension: 29 x 24 x 5 cm
Shop: https://www.artwavewest.com/gallery-artists/helen-slater/
TAKE PART IN NEXT EXHIBITION HEREArtist:Marianne Le Gallo
Email:mariannelegallo.com @mariannelegallostudio
Title:Gunnera Manicata 2021
Details: Glass MFA 2021, Edinburgh College of Art
Price: Price on demand to a gallery/museum where the work will be publicly accessible/exhibited (NFS to private collections).
Dimension: 40cm x 40cm at its widest, 5cm depth & 6.5 Kgs.
Shop: https://www.graduateshow.eca.ed.ac.uk/portfolio/marianne-le-gallo
TAKE PART IN NEXT EXHIBITION HEREArtist:Giles Fearon
Email: gilesfearon1@gmail.com https://gilesfearon1.wixsite.com/gilesfearon
Title:Natural Fluidity
It seemed a natural progression for me to want to represent the ‘mindful breath’ which is an established part of meditative practice.This symbolized for me how this work should be made.
Contact: Manchester Metropolitan University- Three Dimensional Design
Price: £3000 (all three + base)
Dimension: D25-35cm Base: L75cm x W40cm
TAKE PART IN NEXT EXHIBITION HEREArtist:Catherine Dunstan
Email:@catherinedunstanglass www.catherinedunstanglass.co.uk 07955002776 Catherine@catherinedunstanglass.co.uk
Title:Support System
They are jewel-like, imperfect in their irregularity but polished to a full shine. I feel like they’re saying, ‘We tried, we failed; but we showed up anyway.’ The parallel of that feeling to how I feel about my experience of motherhood (which is a big driver behind my practice) was obvious and easy to align. I feel these polished fragments quite literally stand up proudly holding space for the reality of processing difficult experiences, feeling like a failure, and then still showing up.
Details: @catherinedunstanglass www.catherinedunstanglass.co.uk 07955002776 Catherine@catherinedunstanglass.co.uk
Price: (sold as pair) £175
TAKE PART IN NEXT EXHIBITION HEREArtist:Grace Allen
Email: Instagram @Grace.a_crafts https://graceallencrafts.wixsite.com/glass Grace.e.allen98@gmail.com
Title:Coursing Onward
Contact: De Montfort University. Design crafts Ba (Hons)
Dimension: Green piece 120mm tall, top diameter 70mm Pink piece 120mm tall, top diameter 70mm Blue piece 180mm, top diameter 55mm
TAKE PART IN NEXT EXHIBITION HEREArtist:Rosie Perrett
Email:rosieperrett4@gmail.com. Instagram - @rosieperrettdesign. Facebook – RosiePerrettDesign. Artsthreads : https://www.artsthread.com/profile/rosieperrett/
Title:The Influence of Colour.
Contact: Demontfort University, Leicester.
Details: One piece of blown glass work, first image full piece, second image close up. Size of glass work : 18x15cm.
Photo Credit: Matte Studios UK
Dimension: BA Honours in Design Crafts, Class of 2021.
TAKE PART IN NEXT EXHIBITION HEREArtist:Wei Ding
Email:Ins: ding.1117 Facebook: Wei Ding bh70dr@student.sunderland.ac.uk
Title:A Love Letter To Myself
Price: 1500 euros
Photo Credit: Cate Watkinson
Dimension: Glass and Ceramic, 107cm×3cm×107cm
TAKE PART IN NEXT EXHIBITION HEREArtist:Ben Bavin
Email:benbavin.glass@gmail.com https://benbglass.com @benbglass Instagram
Title:SIMULACRUM
Contact: Plymouth College of Art
Details: H40cm W10cm D10cm X5 4800g
Photo Credit: Abbie Gray (@abbiegrayphotography on instagram https://www.abbiegrayphotography.com/ )
Dimension: BA (Hons) Ceramics & Glass
TAKE PART IN NEXT EXHIBITION HEREArtist:Kay Ford
Email:kjford@gmail.com.
Title:Developments in Medicine
University Centre Hastings
1st class honours BA Designer Maker
Dimension: 10cm diameter
Shop: www.kayfordglassandmetal.com
TAKE PART IN NEXT EXHIBITION HEREArtist:Charlie Vinten
Email: charliemichaela99@hotmail.com Instagram: @cvinten_craft Facebook: CVinten Crafting
Title:Take a Breath
Contact: De Montfort University
Details: 5 layers of glass: clear, blue, white and infused flowers, pink and purple, clear.
Price: £225
Photo Credit: Oliver Freemantle
Dimension: 25x10x10cm
TAKE PART IN NEXT EXHIBITION HEREArtist:Sacha Delabre
Email:sachadela@gmail.com sachadelabre.uk @sacha_dela__
Title:Bon Appetit
Price: £200
Photo Credit: Marco Gongalves
TAKE PART IN NEXT EXHIBITION HEREArtist:Luisa Carmen Martin Lopez
Email:lcmartinlopez@gmail.com
Title:The Four Seasons
Photo Credit: Michael Redina
Dimension: Four blocks of 10x7x2 cm each. Printed, over layered and fused glass. One of in Float glass, another in Bullseye and two in Spectrum.
TAKE PART IN NEXT EXHIBITION HEREArtist:Kate Courtney-Taylor
Title:Untethered
Details: kate_courtney_taylor@hotmail.co.uk https://www.katecourtney-taylor.co.uk/
Price: NFS
Dimension: 36x 29 x 70cm (HxDxW)......
TAKE PART IN NEXT EXHIBITION HEREArtist:Georgia Stone
Email:ggstone@hotmail.co.uk www.georgiastoneart.com/bio Instagram: @georgegstone
Title:Dancing Vessels
Contact: Farnham, UCA - Glass, BA (Hons)
Details: Blown Glass, Two vessels, Approx size: On Right (30cm H) On Left (25cm H)
TAKE PART IN NEXT EXHIBITION HEREArtist:Ossin Hanrahan
Email:ossin.hanrahan@mycit.ie https://www.instagram.com/ossinhanrahan/
Title:Meandering lines
In this piece I implemented times tables patterns for the linear designs and the chaos of kiln gods who helped to manipulate the overall shape into something more than I originally planned. This piece has changed several times in an organic way as the materials demanded.
Contact: Crawford College of art and design CIT. BA honours Contemporary Applied Art
Details: cast glass, 23x12x40cm, crystal clear bullseye glass
Price: £6000
Photo Credit: Philip Williums
TAKE PART IN NEXT EXHIBITION HEREArtist:Alison McKenna
Email: alisonmc1985@hotmail.com Instagram: https://www.instagram.com/alison_wonderlandart/
Title:500 Steps : Center & Balance
Contact: National College of Art & Design, Dublin.BA Fine Art.
Details: Collection of 12 A3 Fine Art photographic Prints
Price: €80 per A3 print un- framed
TAKE PART IN NEXT EXHIBITION HEREArtist:Yixue Yang
Email:yangyixuenc@163.com
Title:Unknown
Contact: Facebook: Yixue Young Ins:young.7902
Details: Glass and Mirror
Price: £2500
Photo Credit: Dave Williams
Dimension: 180cm x 160cm x 60cm
TAKE PART IN NEXT EXHIBITION HEREArtist:Jacqui Farrell-Fowler
Email:Jacqui.fowler@btopenworld.com www.jacquifowler.co.uk Inst: @jacquifowlerglass
Title:A meditation on womanhood
Contact: University of Wales, Trinity St David (2017-2020)
Details: BA Hons Architectural Glass (1st Class)
Price: NFS
Dimension: A circular leaded piece, 300mm in diameter. Sandblasted, acid etched and hand painted with vitreous paint and enamels.
TAKE PART IN NEXT EXHIBITION HEREArtist:Áine Ryan
Email:aineryan2015@gmail.com https://aineryanart.wordpress.com/ https://www.instagram.com/aine_ryan_art/
Title:Bound
Contact: MTU Crawford College of Art and Design
Details: cast glass, discarded wellington, scraith sod from nearby bog
Price: €660
Photo Credit: Sean Daly
Dimension: L210cm x W6cm x H5cm
Shop: Bachelor of Arts in Contemporary Applied Art
TAKE PART IN NEXT EXHIBITION HEREArtist:Moonju Suh
Email:monicarhapsody@outlook.com / Instagram: @playful_temperature
Title:Happiness Diary
I believe people often hide their true emotions and personalities. There are many reasons for people hiding their true feelings. But, I argue, one of the most plausible reasons could be that none of us willingly expose their weakness or vulnerabilities.
Contact: Edinburgh College of Art.................. Type of qualification…...........Master of Fine Arts
Price: £1700
Dimension: 9 x 9 x 16 (cm)
TAKE PART IN NEXT EXHIBITION HEREArtist:Belinda King
Email:@bjk_designs on Instagram
Title:Fraternal
Contact: De Montfort University
Price: NFS
Photo Credit: Matte Studio
Dimension: 20cm x 27.5cm
Shop: BA (Hons) Design Crafts
TAKE PART IN NEXT EXHIBITION HEREArtist:Nanu Hodson
Email:nanuhodson223@gmail.com
Title:Design Migration
Although it is of Indian origin, the Paisley was named in Scotland which to me represents the changing nature of design and how it can be translated across cultures.
Contact: Morley College, London
Details: Level 3 BTEC in Art & Design
Photo Credit: Clair Griffiths
Dimension: Uneven strip cut contruction fired within a steel former, the piece is 20cm from tip to base
TAKE PART IN NEXT EXHIBITION HEREArtist:Steven Graham
Email:steven@in-glass.uk https://www.in-glass.uk https://www.facebook.com/stevengrahaminglass/ https://www.instagram.com/steveninglass/
Title:Allison
This panel was commissioned in memory of Allison, who lost her fight with cancer. Having spent time speaking with the client, and listening to the many wonderful stories of Allison, I worked on designs that captured those aspects of her life that were important to her and which resonate her personality:
Yellow roses – These were Allison’s favourite flower and featured in her wedding bouquet
Family names and relevant dates have been entwined into the flourishing rose bush background
VW logo – her love of the classic camper van
Candles – a gift guaranteed to bring a smile to her face
Nice cakes – all friends and family associated a good day out with Allison would involve quality cakes.
Bumble bee – the logo for the Beatson Cancer Centre, Glasgow where Allison received her treatment and for whom she and her friends and family assisted with fund raising
Neck scarves – Allison had a scarf for every occasion, another gift idea
The overall design reflects the client’s interest in the art deco era, and with Alphonse Mucha after their visit to Prague. This design created a foil for so many disparate elements to be combined into a pleasing and respectful aesthetic, which reflects her life and personality.
University of Stirling Batchelor of Arts with Honours in Art & Design
Photo Credit: Ian Marshall
Dimension: 397mm x 447mm
TAKE PART IN NEXT EXHIBITION HEREArtist:Elizabeth Simms
Email:- simmse@hotmail.com - @e.s.design_ (instergram)
Title:Menstr-hood’
(Hand blown Glass, sandblasted, iron filings, sediment)
‘Broken Body of a Bloated Beast’ 2021
(Mould blown glass, life cast, iron filings, sediment)
‘Unstained Youth’ 2021
(Mould blown glass, life cast, sandblasted, iron filings, sediment)
This series features life-sized female body forms casted from the artist herself and mould blown using glass. These three pieces (left to right) ‘Outgrown Home’, ‘Broken Body of a Bloated Beast’ and ‘Unstained Youth’ express the progression of the self from childhood through to puberty. The series was inspired by how it feels to suddenly be faced with dealing with your monthly menstrual cycle and how it can impact the self and body.
This sculptural interpretation of the struggles which come with menstruation aims to initiate and encourage everyone of all genders and ages to share their own experiences and learn from others.
Contact: Plymouth College of Art
Photo Credit: Lorna Absley
Dimension: BA (Hons) 3D Design Crafts
TAKE PART IN NEXT EXHIBITION HEREArtist:Gemma Hollis
Email: @gemmahollisglass Facebook: Gemma Hollis Glass gemmahollisglass@gmail.com
Title:What a bird watcher sees
Left piece- The Bumbarrels. Three sculpted blown glass forms, with pink, black and white spirals. Sitting upon a sustainably sourced yew base
Height:19cm Width: 20cm Depth:14.5cm
Middle- The Nuthatch. Sculpted blown glass form, with blue and light pink spirals. Sitting upon a sustainably sourced yew base.
Height:14cm Width:15cm Depth:10cm
Right- Blackbird. Sculpted blown glass with black and yellow spirals. Sitting upon a sustainably sourced yew base.
Height: 23cm Width:26.5cm Depth: 22cm
Contact: De Montfort University, Leicester Design Crafts Ba (Hons)
Details: The Bumbarrels. Three sculpted blown glass forms, with pink, black and white spirals. Sitting upon a sustainably sourced yew base
Photo Credit: Olly Freemantle
Dimension: H:19cm W: 20cm D:14.5cm H:14cm W:15cm D:10cm H: 23cm W:26.5cm D: 22cm
TAKE PART IN NEXT EXHIBITION HEREArtist:Yixue Yang
Email:yangyixuenc@163.com Facebook: Yixue Young Ins:young.7902
Title:Progression
Details: Glass &ink
Price: £3000
Dimension: 280cm x70cm x25cm
TAKE PART IN NEXT EXHIBITION HEREArtist:Pratibha Mistry
Email:pratibha_mistry@hotmail.co.uk #pratibhamistryglass
Title:Hypoxia (2020)
Contact: University of the Creative Arts. MA Glass
Details: Glass (pâte de verre) mounted with metal dissection pins
Price: NFS
Dimension: 380 x 390 mm
TAKE PART IN NEXT EXHIBITION HEREArtist:Wai Yan Choi
Email:Phone: +85290206984/ 07591541241 Email: Waiyan.choi@network.rca.ac.uk Website: waiyanchoi.com Instagram: https://www.instagram.com/waiyanchoiglass/
Title:Inner Boundaries
Stimutaniously, I used material metaphorically : the flawlwss transparency of glass to represent the environment and the metal to represent man made pollutants that's break the balance of the ecosystem. If combined in certain ways, they are destructive to each other. Yet, under controlled circumstances, environment and human development can coexist and even stimulate something new. I want to use my work to convey a positive vision for the current pandemic and environmental pollution crisis. Our life will return to a new normal, and we can find a way to coexist with nature before the apocalypse arrives.
Contact: Royal College of Arts
Details: 4 x 5 x 7.5 cm per element (Overall dimensions vary with different compositions)
Price: £2500 for the whole set of 23 Cubes and Stands
Photo Credit: Junwei Chen
Dimension: Ceramics and Glass MA 2021
TAKE PART IN NEXT EXHIBITION HERE
